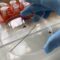
Они не боятся морозов: россиян предупредили о раннем сезоне активности клещей

Около 150 человек продемонстрировали свою силу воли и твердость характера, окатив себя ведром ледяной воды. Редкий случай, когда участников мероприятия оказалось больше чем зрителей. Объединила «моржей на суше «РостехАрена», спортивный праздник провели в честь 80-летия региона и Года единства народов России. Слово Павлу Будникову.
Вот он долгожданный момент, которого некоторые ждали ровно год. Кульминация всего сезона — полторы сотен ведер с ледяной водой продолжают вбирать в себя всю силу и энергию спортивной атмосферы. Из всх участников международной акции «Быть здоровым — это модно» дебютант один – «РостехАрена», у остальных стаж моржевания словно вечная мерзлота.
ВИКТОРИЯ ПОНАМАРЁВА, ЛЮБИТЕЛЬ ПЛАВАНИЯ В ХОЛОДНОЙ ВОДЕ:
— Мы привыкли, мы каждый день в море. Утром – это море, начинается с моря, с воды холодной, круглый год. У нас семья, мы с мужем вдвоем, каждый день в 7:15.
Прежде чем искупаться участники, как и положено профессионалам, проводят разминку. В этом году в акции, зародившейся 10 лет назад, принимают участие 72 города, которые в режиме телемоста одновременно готовятся вылить на себя порцию бодрящего здоровья. Самые экзотичные участники в этом году из Нигерии — туду тоже добрались российские моржи.
АЛИНА СТЕПАНОВА, ОРГАНИЗАТОР АКЦИИ:
— Это нужно просто попробовать, чтобы понять, что на самом деле не так уж и холодно, это здорово! Наверное, всем холодно, но каждый знает, что в итоге все согреются.
Несмотря на оттепель сезон моревания в полном разгаре и завершится он лишь в начале апреля, когда в Славске пройдет чемпионат России по зимнему плаванию. Ожидается, что своих делегатов пришлют 40 российских регионов, а награды турнира разыграют 150 пловцов.
Павел Будников, Олег Почтамцев